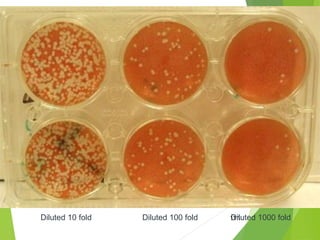
126Diluted 10 fold Diluted 100 fold Diluted 1000 fold

This document provides an overview of virology and viral replication. It begins with an outline of topics to be covered, including the structure and classification of viruses, basic virology, and clinical virology. It then discusses viral structure, noting there are five basic types. Viral replication is summarized in seven steps: adsorption, entry, uncoating, transcription, synthesis of viral components, assembly, and release. Control methods involve knowledge of reservoirs, transmission, inactivation methods, vaccines, antiviral drugs, and drug resistance. Emerging viral diseases and some examples are also mentioned.











































































































![Routes of Transmission
Horizontal transmission:
Direct contact (secretions, blood etc.)
Respiratory (aerosol)
Contaminated inanimate objects
Insect vector (mosquitoes, ticks, etc.)
Zoonoses
Vertical transmission:
Mother to fetus [Transplacental (Congenital), Perinatally]](https://image.slidesharecdn.com/anintroductiontovirology-151107043110-lva1-app6892/85/An-introduction-to-virology-108-320.jpg)